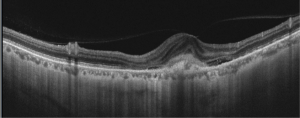

Myopic CNVM
All content on Eyewiki is protected by copyright law and the Terms of Service. This content may not be reproduced, copied, or put into any artificial intelligence program, including large language and generative AI models, without permission from the Academy.
Disease Entity
Disease
Myopia is a major cause of legal blindness and low vision throughout the world, and there is currently a global epidemic of myopia. High myopia refers to a spherical equivalent of -6.0 D or less or an axial length of 26.5 mm or more. Pathological or degenerative myopia refers to a spherical equivalent of -8.0 or less or an axial length of 32.5 mm or more.[1]
Approximately 10% of patients with degenerative myopia will develop a choroidal neovascular membrane (CNVM) over a period of 10-11 years.[2] Around 30% of these patients also develop myopic CNVM in the fellow eye as well. Pathological myopia is the second most common cause of choroidal neovascularization (CNV) after age-related macular degeneration (AMD). It is important to differentiate between the two diseases as their management and outcomes differ.
Pathophysiology
Progressive axial elongation of the eyeball leads to chorioretinal stretching and subsequent thinning of the retina and choroid. Thinned out chorioretinal tissue is associated with poor blood circulation and may lead to CNV development by inducing vascular endothelial growth factor (VEGF) expression.
Risk Factors for CNVM development
Focal chorioretinal atrophy (mainly one disc diameter around fovea), steeper posterior staphyloma, and lacquer cracks are considered as risk factors for myopic CNVM.[2] Patient age, history of previous photodynamic therapy treatment, axial length and visual acuity prior to treatment may affect the treatment prognosis.
Clinical Features
Symptoms: CNVM is a frequent cause of vision loss in patients with myopic degeneration. Patients may complain of metamorphosia, scotoma or decreased vision if CNVM involves the central macula, but they can also be asymptomatic if located outside the macular area. A history of metamorphopsia in myopic patients should arouse a suspicion of CNV.
Signs: Area of retinal atrophy appears as translucent defects with clearly discernible underlying choroidal vessels. Sometimes, bare sclera is visible in these areas. Lacquer cracks are seen as hyperfluorescent streaks with transmission defects in the early and transit phase of fluorescein angiography. The CNVM appears as greyish subretinal lesion (Fig. 1) with hyperpigmented borders. Other features seen in pathological myopia include: peripapillary crescent; attenuation and absence of retinal pigment epithelium; tilting and temporal flattening of the disc; posterior staphyloma; areas of chorioretinal atrophy; lacquer cracks seen as linear breaks in the Bruch’s membrane, most frequently seen in the posterior staphylomatous area; macular or foveal retinoschisis; Fuchs spots; and staightened vessels.
Progression
The progression of myopic CNV evolves through three main stages. In the initial phase, there is direct damage to the photoreceptors, causing central visual loss. Then, as the CNV regresses, a fibrous pigmented scar is formed. Finally, chorioretinal atrophy develops around the regressed CNV, which results in a poor long term visual outcome.
Diagnosis
FFA: CNVM predominantly classic type (i.e. type II CNVM) are observed on FA. However, there is also a high prevalence of occult (Type 1) CNVM in pathological myopic eyes, especially in the Asian subcontinent. In the choroidal phase, more details of vessels are visible due to thinning of overlying RPE. They are seen as well-defined hyperfluorescence often with a hypofluorescent rim of pigmentation in the early phase with progressive leakage of dye in the late phase of the angiogram. The leakage seen in young myopes is milder as compared to the CNVM in AMD. Often a rim of subretinal hemorrhage is seen along the area of CNVM which causes blocked fluorescence.
SD-OCT – Hyper-reflective lesions with fuzzy borders at the RPE, central ellipsoid, and external limiting membrane are seen on SD-OCT imaging. Generally, type 2 CNVM are seen in the pathological myopia cases. Subretinal hemorrhage, intraretinal fluid , subretinal fluid or RPE detachment may also be seen. Enhanced depth imaging (EDI) enables visualization of choroid layers as well which typically demonstrates atrophy in myopic eyes without CNVM and fibrosis or thickening in myopic eyes with CNVM present
SS-OCT – Swept source imaging is particularly useful for diagnosis and follow-up of myopic CNVM. Chorioretinal thinning along with subretinal membrane may be seen in SS-OCT in eyes with myopic CNVM (Fig 2, 3). Better delineation of choroid layers is also possible with SS-OCT.
OCT-A: OCT-A is a non-invasive tool that helps in the differentiation of the subretinal hemorrhage caused by both CNVM and new lacquer crack formation. Active CNV are characterized by a lacy wheel pattern, numerous tiny capillaries, a widely anastomosed network, and a perilesional hypointense halo while quiescent CNV are characterized by long filamentous linear large mature looking vessels, rare anastomosis and a "dead tree" appearance (Fig. 4). OCTA has been found to successfully in detecting up to 94.1% of myopic CNVs.
Differential Diagnosis
- Neovascular AMD
- Myopic macular haemorrhage due to lacquer cracks
- Punctate inner choroidopathy (usually coexists with myopia)
- Presumed ocular histoplasmosis syndrome
- Multifocal choroiditis
- Idiopathic CNV
Management
Since the introduction of anti-VEGF agents in the 2000s, the management of myopic CNVM has shifted from laser-based to pharmacotherapy-based.[3][4][5]
LASER: It was observed that the therapeutic effect of photocoagulation was lost with time and recurrence of new CNVM was observed at the margins of the photocoagulated areas. Heavy use of retinal laser may rarely lead to runoff phenomena where CNVM formation is actually induced, leading to subretinal exudation and neovascularization The photothermal disruption of the retina and the Bruch’s membrane and the formation of new lacquer line may be the predisposing factors for recurrence of CNV. The spread of the photocoagulation scar is more pronounced and rapid in myopic fundi.
PDT: The initial benefits of photodynamic therapy for myopia-associated CNVM were supported in the VIP study[6]. Although initial stability of visual acuity was seen in the initial period, worsening was seen with time.
ANTI-VEGF AGENTS: Today, intravitreal anti-vascular endothelial growth factor (anti-VEGF) is considered as mainstay of therapy in myopic CNVM.[7] The number of anti-VEGF injections required for myopic CNVM are generally lesser than those required for wet ARMD, although variable amongst individual patients.
Major Trials with Anti-VEGF agents in Myopic CNVM
- REPAIR and RADIANCE studies showed efficacy and safety of ranibizumab in this condition. The pro-re-nata (PRN) dosing of ranibizumab was found to be superior to PDT in the RADIANCE study.[8]
- MYRROR study for aflibercept in myopic CNV in Asian population has found it to be safe and effective.[9]
- Bevacizumab is also used to treat myopic CNVM but its intraocular use but is not Food and Drug Administration (FDA) approved.
Follow-Up
Monthly follow up of the patients with monitoring of the visual acuity is important if patients have active or recently-active disease as the risk of recurrent CNVM and development of chorioretinal atrophy is high.
Additional Resources
- Turbert D, Janigian RH. Choroidal Neovascular Membranes . American Academy of Ophthalmology. EyeSmart/Eye health. https://www.aao.org/eye-health/diseases/choroidal-neovascular-membranes-2. Accessed March 07, 2019.
References
- ↑ Basic Clinical and Science Course. Retina and Vitreous. 2013-14. Section 12 pg 85-86
- ↑ 2.0 2.1 Ohno-Matsui K, Yoshida T, Futagami S, Yasuzumi K, Shimada N, Kojima A, et al. Patchy atrophy and lacquer cracks predispose to the development of choroidal neovascularisation in pathological myopia. Br J Ophthalmol. 2003 May;87(5):570–3.
- ↑ Adatia FA, Luong M, Munro M, Tufail A. The other CNVM: A review of myopic choroidal neovascularization treatment in the age of anti-vascular endothelial growth factor agents. Survey of Ophthalmology. 2015 May;60(3):204–15.
- ↑ Wong TY, Ohno-Matsui K, Leveziel N, Holz FG, Lai TY, Yu HG, et al. Myopic choroidal neovascularisation: current concepts and update on clinical management. Br J Ophthalmol. 2015 Mar;99(3):289–96.
- ↑ Kumar A, Chawla R, Kumawat D, Pillay G. Insight into high myopia and the macula. Indian Journal of Ophthalmology. 2017;65(2):85.
- ↑ Blinder KJ, Blumenkranz MS, Bressler NM, et al. Verteporfin therapy of subfoveal choroidal neovascularization in pathologic myopia: 2-year results of a randomized clinical trial--VIP report no. 3. Ophthalmology. 2003 Apr;110(4):667-73.
- ↑ Tan CS, Sadda SR. Anti-vascular endothelial growth factor therapy for the treatment of myopic choroidal neovascularization. Clinical Ophthalmology (Auckland, NZ). 2017;11:1741–6.
- ↑ Wolf S, Balciuniene VJ, Laganovska G, et al. RADIANCE: a randomized controlled study of ranibizumab in patients with choroidalneovascularization secondary to pathologic myopia. Ophthalmology. 2014 Mar;121(3):682-92.e2. doi: 10.1016/j.ophtha.2013.10.023. Epub 2013 Dec 8.
- ↑ Ikuno Y, Ohno-Matsui K, Wong TY, Intravitreal Aflibercept Injection in Patients with Myopic Choroidal Neovascularization: The MYRROR Study. Ophthalmology. 2015 Jun;122(6):1220-7. doi: 10.1016/j.ophtha.2015.01.025. Epub 2015 Mar 4.